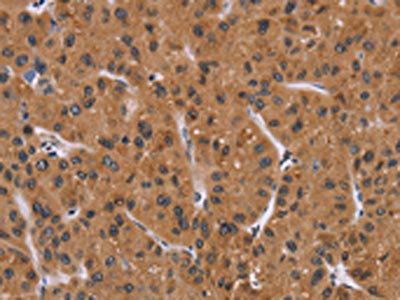

PPIB Antibody
-
中文名稱:PPIB兔多克隆抗體
-
貨號(hào):CSB-PA906437
-
規(guī)格:¥1100
-
圖片:
-
The image on the left is immunohistochemistry of paraffin-embedded Human cervical cancer tissue using CSB-PA906437(PPIB Antibody) at dilution 1/40, on the right is treated with fusion protein. (Original magnification: ×200)
-
The image on the left is immunohistochemistry of paraffin-embedded Human liver cancer tissue using CSB-PA906437(PPIB Antibody) at dilution 1/40, on the right is treated with fusion protein. (Original magnification: ×200)
-
Gel: 10%SDS-PAGE, Lysate: 40 μg, Lane 1-4: Human fetal liver tissue, 293T cells, human liver cancer tissue, hela cells, Primary antibody: CSB-PA906437(PPIB Antibody) at dilution 1/450, Secondary antibody: Goat anti rabbit IgG at 1/8000 dilution, Exposure time: 20 seconds
-
-
其他:
產(chǎn)品詳情
-
Uniprot No.:
-
基因名:PPIB
-
別名:AA408962 antibody; AA553318 antibody; AI844835 antibody; Cphn 2 antibody; Cphn2 antibody; Cyclophilin B antibody; Cyclophilin like protein antibody; CyP 20b antibody; CYP S1 antibody; CYP-S1 antibody; CYPB antibody; EC 5.2.1.8 antibody; MGC14109 antibody; MGC2224 antibody; OI9 antibody; peptidyl prolyl cis trans isomerase B antibody; Peptidyl prolyl cis trans isomerase B precursor antibody; Peptidyl-prolyl cis-trans isomerase B antibody; peptidylprolyl isomerase B (cyclophilin B) antibody; Peptidylprolyl isomerase B antibody; PPIase antibody; PPIase B antibody; Ppib antibody; PPIB_HUMAN antibody; Rotamase antibody; Rotamase B antibody; S cyclophilin antibody; S-cyclophilin antibody; SCYLP antibody
-
宿主:Rabbit
-
反應(yīng)種屬:Human,Mouse,Rat
-
免疫原:Fusion protein of Human PPIB
-
免疫原種屬:Homo sapiens (Human)
-
標(biāo)記方式:Non-conjugated
-
抗體亞型:IgG
-
純化方式:Antigen affinity purification
-
濃度:It differs from different batches. Please contact us to confirm it.
-
保存緩沖液:-20°C, pH7.4 PBS, 0.05% NaN3, 40% Glycerol
-
產(chǎn)品提供形式:Liquid
-
應(yīng)用范圍:ELISA,WB,IHC
-
推薦稀釋比:
Application Recommended Dilution ELISA 1:2000-1:5000 WB 1:500-1:2000 IHC 1:100-1:300 -
Protocols:
-
儲(chǔ)存條件:Upon receipt, store at -20°C or -80°C. Avoid repeated freeze.
-
貨期:Basically, we can dispatch the products out in 1-3 working days after receiving your orders. Delivery time maybe differs from different purchasing way or location, please kindly consult your local distributors for specific delivery time.
-
用途:For Research Use Only. Not for use in diagnostic or therapeutic procedures.
相關(guān)產(chǎn)品
靶點(diǎn)詳情
-
功能:PPIase that catalyzes the cis-trans isomerization of proline imidic peptide bonds in oligopeptides and may therefore assist protein folding.
-
基因功能參考文獻(xiàn):
- A graphene-based nanocarrier modified with death receptor 4 (DR4) antibody and AKT siRNA has been developed, which can synergistically strengthen death receptor-mediated apoptosis and enhance the cancer therapeutic effect in vivo. PMID: 30430148
- Data show that Cyclophilin B is present on the erythrocytes and binds strongly to merozoites. PMID: 29146974
- cyclophilin B (CYPB) functions in protecting cells against aldosterone-induced oxidative stress, endoplasmic reticulum stress (ERS) and tubular cell injury via its peptidyl-prolyl cis-trans isomerase (PPIase) activity. PMID: 27732567
- PPIB mutations and their associated phenotypes PMID: 28242392
- observed changes in activity of six rER-resident PPIases, cyclophilin B (encoded by the PPIB gene), FKBP13 (FKBP2), FKBP19 (FKBP11), FKBP22 (FKBP14), FKBP23 (FKBP7), and FKBP65 (FKBP10), due to posttranslational modifications of proline residues in the substrate. PMID: 28385890
- The data suggest that overexpressed CypB protects neuronal cells from MPP+-induced dopaminergic neuronal cell death PMID: 27569281
- This study enhances our knowledge about the mutational pattern of the LEPRE1, CRTAP, and PPIB genes. LEPRE1 should be the first gene analyzed in mutation detection studies in patients with recessive OI. PMID: 26634552
- Over-expression of CypB enhances HIV infection by increasing nuclear import of viral DNA. PMID: 26774171
- Cyclophilin B has a high diagnostic value for stomach cancer and its downregulation can effectively inhibit the growth of stomach cancer cells. Thus, cyclophilin B may be a potential therapeutic target for stomach cancer treatment PMID: 26125731
- The extracellular portion of cyclophilin B probably plays an important role in human diseases associated with acute or chronic inflammation PMID: 24713575
- Findings demonstrate that CypB prevents hypoxia-induced cell death through modulation of ubiquitin-mediated CHOP protein degradation, suggesting that CypB may have an important role in the tight regulation of CHOP under hypoxia. PMID: 24270407
- These findings establish cyclophilin C as an ER cyclophilin, demonstrate the novel involvement of cyclophilins B and C in ER redox homeostasis PMID: 24990953
- Cyclophilin B is a novel MDM2 interacting partner. PMID: 24583282
- cyclophilin B (CypB) is a prolyl isomerase residing in the endoplasmic reticulum (ER), that provides an essential survival signal in glioblastoma multiforme cells through myc and mutant p53 PMID: 24272483
- An additional function of the rough endoplasmic reticulum protein complex prolyl 3-hydroxylase 1.cartilage-associated protein.cyclophilin B: the CXXXC motif reveals disulfide isomerase activity in vitro. PMID: 24043621
- Cyclophilin B activity regulated secretion and activity of ADAMTS13. PMID: 23144461
- CypB has an essential function in protecting hepatoma cells against oxidative stress through binding to CD147 and regulating the ERK pathway PMID: 22555451
- these findings suggest an unexpected role for cyclophilin B in attenuation of the responses of proinflammatory macrophages PMID: 22798670
- CypB interacts with these proteins and is involved in ribosome biogenesis and RNA transcription. PMID: 22426501
- Cyclophilin B is a candidate pancreatic cancer biomarker. PMID: 22484812
- CypB induced by hypoxia stimulates the survival of hepatocellular carcinoma via a positive feedback loop with HIF-1alpha. PMID: 21748762
- CAHL is a CsA associated helicase-like protein, which would form trimer complex with cyclophilin B and NS5B of HCV PMID: 21559518
- peptidylprolyl cis-trans isomerase B may be required to effectively fold the proline-rich regions of the C-terminal propeptide of procollagen PMID: 21282188
- cyclophilin isoform B is likely responsible for down-regulation of carrier expression by CsA and that it does so via its chaperone activity on NaDC1 (by direct interaction) rather than its rotamase activity. PMID: 21257749
- These results suggest that CypB plays a crucial role in the replication of Japanese encephalitis virus through an interaction with NS4A. PMID: 21281954
- Data indicate that CypB through its interaction with Na/K-beta1 might regulate maturation and trafficking of the pump through the secretory pathway. PMID: 21085665
- Results reveal the P-domain functions as a unique protein-protein interaction domain and implicate a peptidyl prolyl isomerase as a new element in the calnexin cycle. PMID: 20801878
- Cyclophilin B significantly modulate prolactin-induced function in breast cancer cells, ultimately resulting in enhanced levels of prolactin-responsive gene expression, cell growth, and migration. PMID: 20237142
- a regulatory mechanism in which cell type-specific expression of certain heparan sulfate sulfotransferases determines the specific binding of CyPB to target cells PMID: 19940140
- calcium signaling through CD147 receptor; induces neutrophil chemotaxis PMID: 11688976
- act in the context of t lymphocyte recruitment and function PMID: 11867726
- Different regions of CyPB are involved in peripheral blood T-lymphocyte activation and imply an important physiological function for peptidylprolyl isomerase activity. PMID: 11955071
- Inhibition of the PT-pore (ANT-1) via up-regulation of cyclophilin D plays a role in tumorigenesis PMID: 14729611
- Cyclophilin B plays a critical role in the activation of interferon regulatory factor-3. PMID: 15764595
- CYPB is a functional rfegulator of hepacivirus RNA polymerase. PMID: 15989969
- results strongly support the hypothesis that 3-O-sulfation of GlcNH2 residues could be a key modification that provides specialized HS structures for CyPB binding to responsive cells PMID: 17588944
- Altogether, our results support a model whereby CyPB induces integrin-mediated adhesion via interaction with a multimolecular unit formed by the association between CD147, CD98 and beta1 integrins. PMID: 18054915
- CypB is a new TRPV6 accessory protein with potential involvement in TRPV6 channel activation through its peptidyl-prolyl cis/trans isomerase activity PMID: 18445599
- the enhanced expression of CypB in malignant breast epithelium may contribute to the pathogenesis of this disease PMID: 19056847
- PPIB mutations cause severe osteogenesis imperfecta PMID: 19781681
顯示更多
收起更多
-
相關(guān)疾病:Osteogenesis imperfecta 9 (OI9)
-
亞細(xì)胞定位:Virion.
-
蛋白家族:Cyclophilin-type PPIase family, PPIase B subfamily
-
數(shù)據(jù)庫(kù)鏈接:
Most popular with customers
-
-
YWHAB Recombinant Monoclonal Antibody
Applications: ELISA, WB, IHC, IF, FC
Species Reactivity: Human, Mouse, Rat
-
Phospho-YAP1 (S127) Recombinant Monoclonal Antibody
Applications: ELISA, WB, IHC
Species Reactivity: Human
-
-
-
-
-